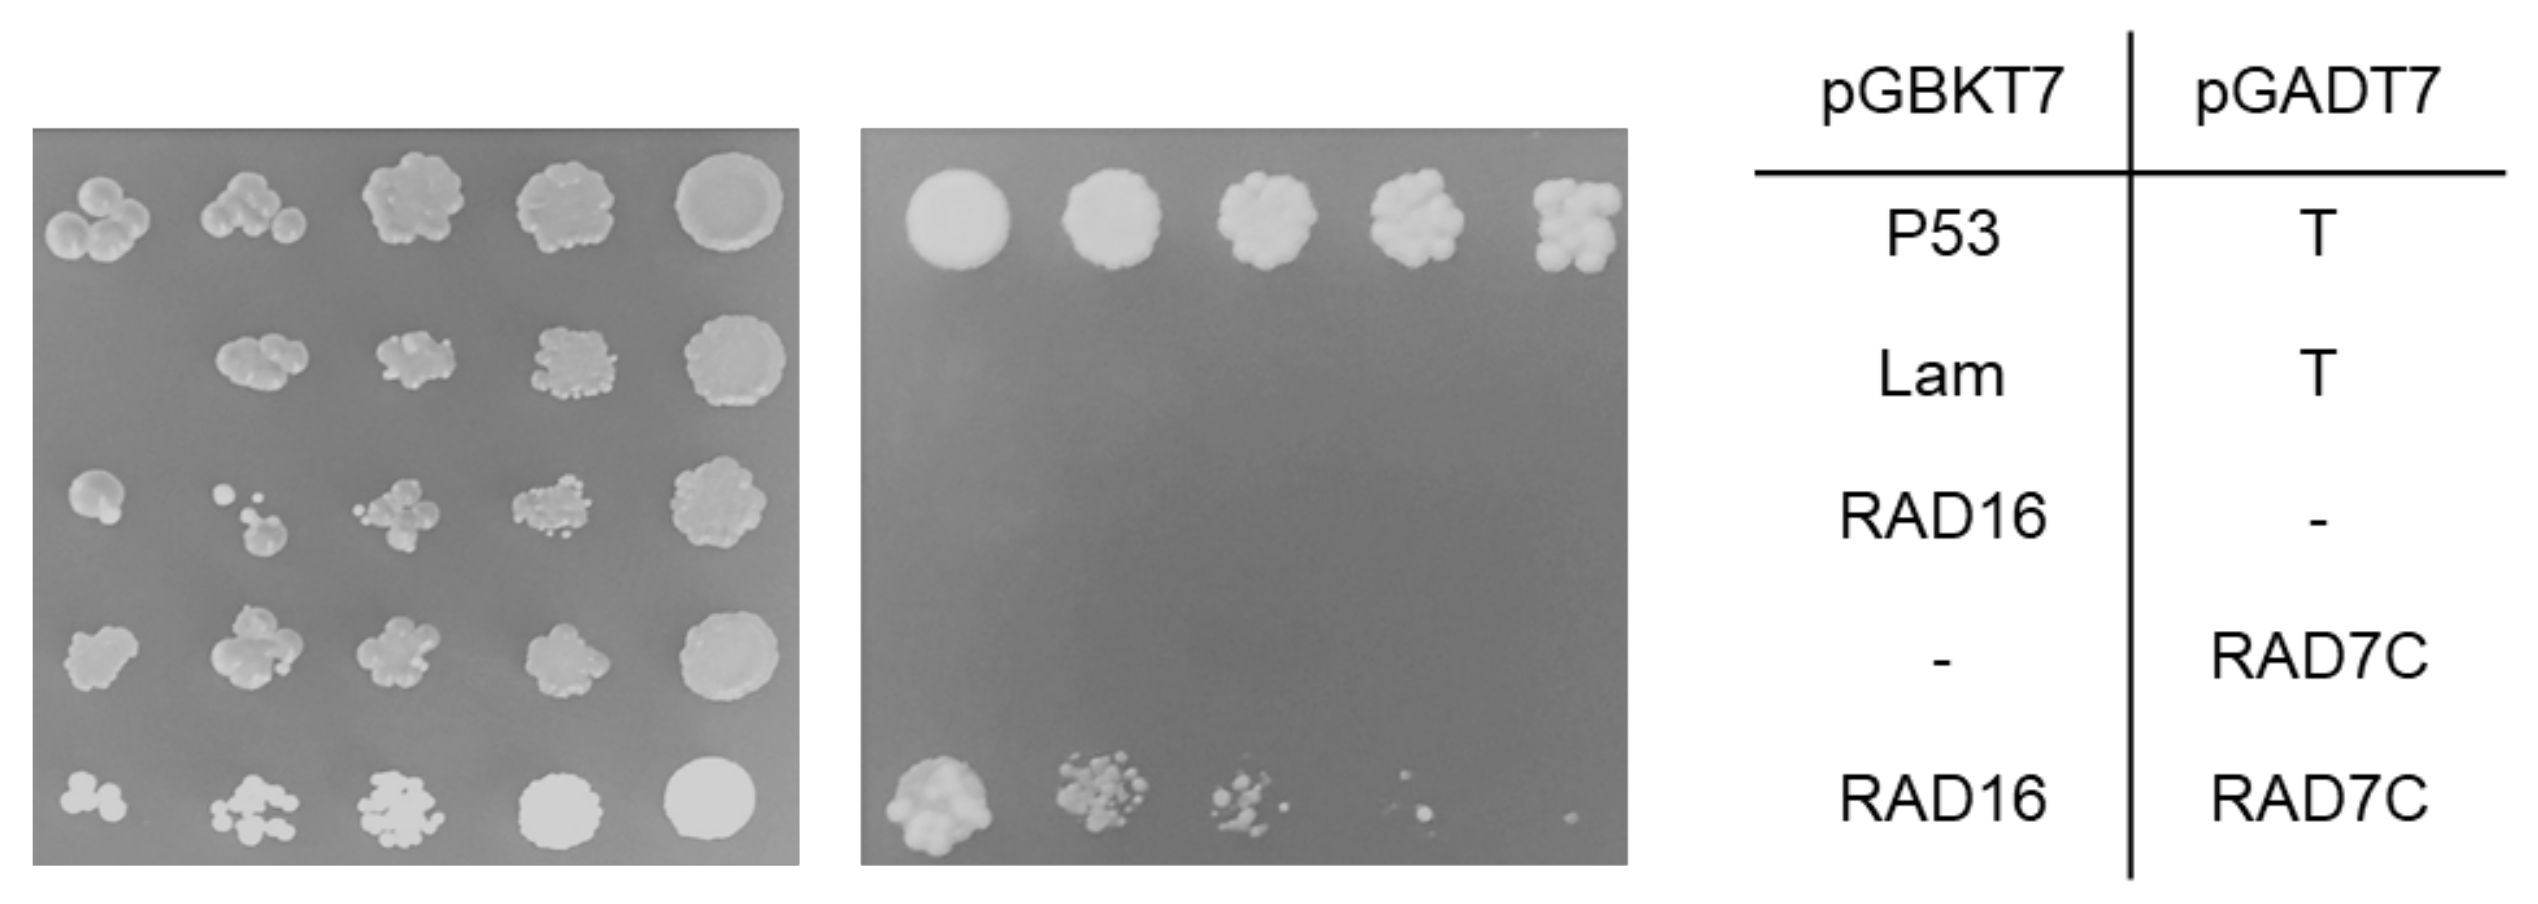
Genes 14 01552 g009 Genes 14 01552 g009

Arabidopsis RAD16 Homologues Are Involved in UV Tolerance and Growth
Abstract
1. Introduction
2. Materials and Methods
2.1. Sequence Analysis
2.2. Plant Materials and Growth Conditions
2.3. RNA Extraction and RT-PCR
2.4. UV Sensitivity Assays
2.5. Adult Growth and Developmental Parameters
2.6. Generation of RAD16 Overexpression Lines
2.7. Protein Subcellular Localization
2.8. Yeast Two-Hybrid Screening
2.9. Generation of Double Mutant Plants
2.10. Statistical Analysis
3. Results
3.1. Arabidopsis RAD16 Proteins Are Homologous to Yeast RAD16 Proteins
3.2. Arabidopsis RAD16s Are Expressed during Development and in Response to UV Radiation
3.3. Arabidopsis rad16 and rad16b Mutants Exhibit Increased UV Sensitivity
3.4. Arabidopsis rad16 and rad16b UV Sensitivity Is Dark-Specific
3.5. Lacking either AtRAD16 or AtRAD16b Results in Early Flowering Time and Short Silique Length
3.6. AtRAD16 Overexpression Rescues the UV-Sensitivity and Adult Developmental Phenotypes Exhibited by Atrad16 Null Mutant and Increases UV Tolerance
3.7. Arabidopsis RAD16 Exhibits Nuclear Localization That Is Not Changed by UV Treatment
3.8. Arabidopsis RAD16 Physically Interacts with Arabidopsis RAD7a and RAD7c
3.9. Arabidopsis rad16 rad7a and rad7a rad7c Double Null Mutant Plants Are More Sensitive to UV Radiation Than Single Mutants
3.10. Lacking Both Arabidopsis RAD16 and RAD23b Results in Embryo Lethality
3.11. RAD7/16 Damage Recognition Module Makes a Significant Contribution to Arabidopsis NER Compared to the DDB1/2 Module
3.12. The RAD7/16 Pathway Makes a Significant Contribution to Arabidopsis NER Compared to the CSB Pathway
4. Discussion
4.1. Suggested Conserved Function of Arabidopsis RAD16s in DNA Repair
4.2. Arabidopsis RAD16s Are Required for GG-NER (Dark Repair)
4.3. Regulation of Developmental Processes
4.4. Overexpression of NER Components
4.5. Cellular Localization of NER Components
4.6. Suggested Role for Arabidopsis RAD7/16 Complex in GG-NER
4.7. AtRAD16 and AtRAD7 Are Involved in UV Tolerance
4.8. Arabidopsis RAD16 and RAD23 Are Required for Embryo Development
4.9. Both RAD7/16 and DDB1/2 Damage Recognition Modules Contribute to Arabidopsis UV Tolerance
4.10. Both Arabidopsis RAD16 and CSB/UVSSA Contribute to Plant UV Tolerance and CSB/UVSSA Pathway Is More Essential at Early Developmental Stages
Supplementary Materials
Author Contributions
Funding
Informed Consent Statement
Conflicts of Interest
References
- Mullenders, L. Solar UV damage to cellular DNA: From mechanisms to biological effects. Photochem. Photobiol. Sci. 2018, 17, 1842–1852. [Google Scholar] [CrossRef]
- Essen, L.O.; Klar, T. Light-driven DNA repair by photolyases. Cell. Mol. Life Sci. CMLS 2006, 63, 1266–1277. [Google Scholar] [CrossRef] [PubMed]
- Petruseva, I.O.; Evdokimov, A.N.; Lavrik, O.I. Molecular mechanism of global genome nucleotide excision repair. Acta Naturae 2014, 6, 23–34. [Google Scholar] [CrossRef]
- Ganpudi, A.L.; Schroeder, D.F. UV Damaged DNA Repair & Tolerance in Plants. In Selected Topics in DNA Repair; IntechOpen: London, UK, 2011. [Google Scholar] [CrossRef]
- Rastogi, R.P.; Richa; Kumar, A.; Tyagi, M.B.; Sinha, R.P. Molecular mechanisms of ultraviolet radiation-induced DNA damage and repair. J. Nucleic Acids 2010, 2010, 592980. [Google Scholar] [CrossRef] [PubMed]
- Spampinato, C.P. Protecting DNA from errors and damage: An overview of DNA repair mechanisms in plants compared to mammals. Cell. Mol. Life Sci CMLS 2017, 74, 1693–1709. [Google Scholar] [CrossRef] [PubMed]
- Shuck, S.C.; Short, E.A.; Turchi, J.J. Eukaryotic nucleotide excision repair: From understanding mechanisms to influencing biology. Cell Res. 2008, 18, 64–72. [Google Scholar] [CrossRef] [PubMed]
- Vermeulen, W.; Fousteri, M. Mammalian transcription-coupled excision repair. Cold Spring Harb. Perspect. Biol. 2013, 5, a012625. [Google Scholar] [CrossRef] [PubMed]
- Henning, K.A.; Li, L.; Iyer, N.; McDaniel, L.D.; Reagan, M.S.; Legerski, R.; Schultz, R.A.; Stefanini, M.; Lehmann, A.R.; Mayne, L.V.; et al. The Cockayne syndrome group A gene encodes a WD repeat protein that interacts with CSB protein and a subunit of RNA polymerase II TFIIH. Cell 1995, 82, 555–564. [Google Scholar] [CrossRef]
- Spivak, G. Transcription-coupled repair: An update. Arch. Toxicol. 2016, 90, 2583–2594. [Google Scholar] [CrossRef]
- Tatum, D.; Li, S. Nucleotide excision repair in S. cerevisiae. In DNA Repair; Storici, F., Ed.; IntechOpen: London, UK, 2011; pp. 97–122. [Google Scholar]
- Sugasawa, K. Molecular mechanisms of DNA damage recognition for mammalian nucleotide excision repair. DNA Repair 2016, 44, 110–117. [Google Scholar] [CrossRef]
- Wang, H.; Zhai, L.; Xu, J.; Joo, H.Y.; Jackson, S.; Erdjument-Bromage, H.; Tempst, P.; Xiong, Y.; Zhang, Y. Histone H3 and H4 ubiquitylation by the CUL4-DDB-ROC1 ubiquitin ligase facilitates cellular response to DNA damage. Mol. Cell 2006, 22, 383–394. [Google Scholar] [CrossRef] [PubMed]
- El-Mahdy, M.A.; Zhu, Q.; Wang, Q.E.; Wani, G.; Prætorius-Ibba, M.; Wani, A.A. Cullin 4A-mediated proteolysis of DDB2 protein at DNA damage sites regulates in vivo lesion recognition by XPC. J. Biol. Chem. 2006, 281, 13404–13411. [Google Scholar] [CrossRef] [PubMed]
- Nishi, R.; Okuda, Y.; Watanabe, E.; Mori, T.; Iwai, S.; Masutani, C.; Sugasawa, K.; Hanaoka, F. Centrin 2 stimulates nucleotide excision repair by interacting with xeroderma pigmentosum group C protein. Mol. Cell. Biol. 2005, 25, 5664–5674. [Google Scholar] [CrossRef] [PubMed]
- Reed, S.H. Nucleotide excision repair in chromatin: The shape of things to come. DNA Repair 2005, 4, 909–918. [Google Scholar] [CrossRef]
- Gillette, T.G.; Yu, S.; Zhou, Z.; Waters, R.; Johnston, S.A.; Reed, S.H. Distinct functions of the ubiquitin-proteasome pathway influence nucleotide excision repair. EMBO J. 2006, 25, 2529–2538. [Google Scholar] [CrossRef] [PubMed]
- Lahari, T.; Lazaro, J.; Schroeder, D. RAD4 and RAD23/HMR Contribute to Arabidopsis UV Tolerance. Genes 2017, 9, 8. [Google Scholar] [CrossRef]
- Molinier, J.; Ramos, C.; Fritsch, O.; Hohn, B. CENTRIN2 modulates homologous recombination and nucleotide excision repair in Arabidopsis. Plant Cell 2004, 16, 1633–1643. [Google Scholar] [CrossRef]
- Ganpudi, A.L.; Schroeder, D.F. Genetic interactions of Arabidopsis thaliana damaged DNA binding protein 1B (DDB1B) with DDB1A, DET1, and COP1. G3 2013, 3, 493–503. [Google Scholar] [CrossRef]
- Li, X.; Guo, X.; Zhao, L.; Zhang, J.; Tang, D.; Zhao, X.; Liu, X. Arabidopsis rad23-4 gene is required for pollen development under UV-B light. Afr. J. Biotechnol. 2012, 11, 10161–10169. [Google Scholar]
- Al Khateeb, W.M.; Schroeder, D.F. Overexpression of Arabidopsis damaged DNA binding protein 1A (DDB1A) enhances UV tolerance. Plant Mol. Biol. 2009, 70, 371–383. [Google Scholar] [CrossRef]
- Molinier, J.; Lechner, E.; Dumbliauskas, E.; Genschik, P. Regulation and role of Arabidopsis CUL4-DDB1A-DDB2 in maintaining genome integrity upon UV stress. PLoS Genet. 2008, 4, e1000093. [Google Scholar] [CrossRef] [PubMed]
- Lahari, T.; Lazaro, J.; Marcus, J.M.; Schroeder, D.F. RAD7 homologues contribute to Arabidopsis UV tolerance. Plant Sci. Int. J. Exp. Plant Biol. 2018, 277, 267–277. [Google Scholar] [CrossRef] [PubMed]
- Shaked, H.; Avivi-Ragolsky, N.; Levy, A.A. Involvement of the Arabidopsis SWI2/SNF2 chromatin remodeling gene family in DNA damage response and recombination. Genetics 2006, 173, 985–994. [Google Scholar] [CrossRef] [PubMed]
- Weber, H.; Bernhardt, A.; Dieterle, M.; Hano, P.; Mutlu, A.; Estelle, M.; Genschik, P.; Hellmann, H. Arabidopsis AtCUL3a and AtCUL3b form complexes with members of the BTB/POZ-MATH protein family. Plant Physiol. 2005, 137, 83–93. [Google Scholar] [CrossRef]
- Jain, M.; Nijhawan, A.; Tyagi, A.K.; Khurana, J.P. Validation of housekeeping genes as internal control for studying gene expression in rice by quantitative real-time PCR. Biochem. Biophys. Res. Commun. 2006, 345, 646–651. [Google Scholar] [CrossRef]
- Hossain, Z.; Amyot, L.; McGarvey, B.; Gruber, M.; Jung, J.; Hannoufa, A. The translation elongation factor eEF-1Bβ1 is involved in cell wall biosynthesis and plant development in Arabidopsis thaliana. PLoS ONE 2012, 7, e30425. [Google Scholar] [CrossRef]
- Earley, K.W.; Haag, J.R.; Pontes, O.; Opper, K.; Juehne, T.; Song, K.; Pikaard, C.S. Gateway-compatible vectors for plant functional genomics and proteomics. Plant J. Cell Mol. Biol. 2006, 45, 616–629. [Google Scholar] [CrossRef]
- Weigel, D.; Glazebrook, J. Vectors and agrobacterium hosts for Arabidopsis transformation. CSH Protoc. 2006, 2006, pdb.ip29. [Google Scholar] [CrossRef]
- Bucevičius, J.; Lukinavičius, G.; Gerasimaitė, R. The use of Hoechst dyes for DNA staining and beyond. Chemosensors 2018, 6, 18. [Google Scholar] [CrossRef]
- Lu, Q.; Tang, X.; Tian, G.; Wang, F.; Liu, K.; Nguyen, V.; Kohalmi, S.E.; Keller, W.A.; Tsang, E.W.T.; Harada, J.J.; et al. Arabidopsis homolog of the yeast TREX-2 mRNA export complex: Components and anchoring nucleoporin. Plant J. 2010, 61, 259–270. [Google Scholar] [CrossRef]
- Delwiche, C.F.; Cooper, E.D. The Evolutionary Origin of a Terrestrial Flora. Curr. Biol. 2015, 25, R899–R910. [Google Scholar] [CrossRef]
- Heinicke, S.; Livstone, M.S.; Lu, C.; Oughtred, R.; Kang, F.; Angiuoli, S.V.; White, O.; Botstein, D.; Dolinski, K. The Princeton Protein Orthology Database (P-POD): A comparative genomics analysis tool for biologists. PLoS ONE 2007, 2, e766. [Google Scholar] [CrossRef]
- Mistry, J.; Chuguransky, S.; Williams, L.; Qureshi, M.; Salazar, G.A.; Sonnhammer, E.L.; Tosatto, S.C.E.; Paladin, L.; Raj, S.; Richardson, L.J.; et al. Pfam: The protein families database in 2021. Nucleic Acids Res. 2021, 49, D412–D419. [Google Scholar] [CrossRef]
- Yu, S.; Evans, K.; van Eijk, P.; Bennett, M.; Webster, R.M.; Leadbitter, M.; Teng, Y.; Waters, R.; Jackson, S.P.; Reed, S.H. Global genome nucleotide excision repair is organized into domains that promote efficient DNA repair in chromatin. Genome Res. 2016, 26, 1376–1387. [Google Scholar] [CrossRef]
- Schmid, M.; Davison, T.S.; Henz, S.R.; Pape, U.J.; Demar, M.; Vingron, M.; Schölkopf, B.; Weigel, D.; Lohmann, J.U. A gene expression map of Arabidopsis thaliana development. Nat. Genet. 2005, 37, 501–506. [Google Scholar] [CrossRef]
- Kilian, J.; Whitehead, D.; Horak, J.; Wanke, D.; Weinl, S.; Batistic, O.; D’Angelo, C.; Bornberg-Bauer, E.; Kudla, J.; Harter, K. The AtGenExpress global stress expression data set: Protocols, evaluation and model data analysis of UV-B light, drought and cold stress responses. Plant J. Cell Mol. Biol. 2007, 50, 347–363. [Google Scholar] [CrossRef]
- Lombaerts, M.; Peltola, P.H.; Visse, R.; den Dulk, H.; Brandsma, J.A.; Brouwer, J. Characterization of the rhp7(+) and rhp16(+) genes in Schizosaccharomyces pombe. Nucleic Acids Res. 1999, 27, 3410–3416. [Google Scholar] [CrossRef][Green Version]
- Bang, D.D.; Timmermans, V.; Verhage, R.; Zeeman, A.M.; van de Putte, P.; Brouwer, J. Regulation of the Saccharomyces cerevisiae DNA repair gene RAD16. Nucleic Acids Res. 1995, 23, 1679–1685. [Google Scholar] [CrossRef][Green Version]
- Geisler-Lee, J.; O’Toole, N.; Ammar, R.; Provart, N.J.; Millar, A.H.; Geisler, M. A predicted interactome for Arabidopsis. Plant Physiol. 2007, 145, 317–329. [Google Scholar] [CrossRef]
- Warde-Farley, D.; Donaldson, S.L.; Comes, O.; Zuberi, K.; Badrawi, R.; Chao, P.; Franz, M.; Grouios, C.; Kazi, F.; Lopes, C.T.; et al. The GeneMANIA prediction server: Biological network integration for gene prioritization and predicting gene function. Nucleic Acids Res. 2010, 38, W214–W220. [Google Scholar] [CrossRef] [PubMed]
- Al Khateeb, W.M.; Sher, A.A.; Marcus, J.M.; Schroeder, D.F. UVSSA, UBP12, and RDO2/TFIIS Contribute to Arabidopsis UV Tolerance. Front. Plant Sci. 2019, 10, 516. [Google Scholar] [CrossRef]
- Li, S.; Ding, B.; LeJeune, D.; Ruggiero, C.; Chen, X.; Smerdon, M.J. The roles of Rad16 and Rad26 in repairing repressed and actively transcribed genes in yeast. DNA Repair 2007, 6, 1596–1606. [Google Scholar] [CrossRef] [PubMed]
- Mastro, T.L.; Forsburg, S.L. Increased meiotic crossovers and reduced genome stability in absence of Schizosaccharomyces pombe Rad16 (XPF). Genetics 2014, 198, 1457–1472. [Google Scholar] [CrossRef] [PubMed]
- Liu, L.; Huo, Y.; Li, J.; Jiang, T. Crystal structure of the yeast Rad7-Elc1 complex and assembly of the Rad7-Rad16-Elc1-Cul3 complex. DNA Repair 2019, 77, 1–9. [Google Scholar] [CrossRef]
- Guzder, S.N.; Sung, P.; Prakash, L.; Prakash, S. The DNA-dependent ATPase activity of yeast nucleotide excision repair factor 4 and its role in DNA damage recognition. J. Biol. Chem. 1998, 273, 6292–6296. [Google Scholar] [CrossRef]
- Dieterle, M.; Thomann, A.; Renou, J.P.; Parmentier, Y.; Cognat, V.; Lemonnier, G.; Müller, R.; Shen, W.H.; Kretsch, T.; Genschik, P. Molecular and functional characterization of Arabidopsis Cullin 3A. Plant J. Cell Mol. Biol. 2005, 41, 386–399. [Google Scholar] [CrossRef]
- Christians, M.J.; Gingerich, D.J.; Hua, Z.; Lauer, T.D.; Vierstra, R.D. The light-response BTB1 and BTB2 proteins assemble nuclear ubiquitin ligases that modify phytochrome B and D signaling in Arabidopsis. Plant Physiol. 2012, 160, 118–134. [Google Scholar] [CrossRef] [PubMed]
- Thomann, A.; Brukhin, V.; Dieterle, M.; Gheyeselinck, J.; Vantard, M.; Grossniklaus, U.; Genschik, P. Arabidopsis CUL3A and CUL3B genes are essential for normal embryogenesis. Plant J. 2005, 43, 437–448. [Google Scholar] [CrossRef]
- Guzder, S.N.; Sung, P.; Prakash, L.; Prakash, S. Yeast Rad7-Rad16 complex, specific for the nucleotide excision repair of the nontranscribed DNA strand, is an ATP-dependent DNA damage sensor. J. Biol. Chem. 1997, 272, 21665–21668. [Google Scholar] [CrossRef]
- Liang, L.; Flury, S.; Kalck, V.; Hohn, B.; Molinier, J. CENTRIN2 interacts with the Arabidopsis homolog of the human XPC protein (AtRAD4) and contributes to efficient synthesis-dependent repair of bulky DNA lesions. Plant Mol. Biol. 2006, 61, 345–356. [Google Scholar] [CrossRef]
- Liu, L.; Zhang, Z.; Mei, Q.; Chen, M. PSI: A comprehensive and integrative approach for accurate plant subcellular localization prediction. PLoS ONE 2013, 8, e75826. [Google Scholar] [CrossRef]
- Hooper, C.M.; Castleden, I.R.; Tanz, S.K.; Aryamanesh, N.; Millar, A.H. SUBA4: The interactive data analysis centre for Arabidopsis subcellular protein locations. Nucleic Acids Res. 2017, 45, D1064–D1074. [Google Scholar] [CrossRef]
- Kosugi, S.; Hasebe, M.; Tomita, M.; Yanahawa, H. Systematic identification of cell cycle-dependent yeast nucleocytoplasmic shuttling proteins by prediction of composite motifs. Proc. Natl. Acad. Sci. USA 2009, 106, 10171–10176. [Google Scholar] [CrossRef]
- Biedermann, S.; Hellmann, H. The DDB1a interacting proteins ATCSA-1 and DDB2 are critical factors for UV-B tolerance and genomic integrity in Arabidopsis thaliana. Plant J. Cell Mol. Biol. 2010, 62, 404–415. [Google Scholar] [CrossRef] [PubMed]
- Tkach, J.M.; Yimit, A.; Lee, A.Y.; Riffle, M.; Costanzo, M.; Jaschob, D.; Hendry, J.A.; Ou, J.; Moffat, J.; Boone, C.; et al. Dissecting DNA damage response pathways by analysing protein localization and abundance changes during DNA replication stress. Nat. Cell Biol. 2012, 14, 966–976. [Google Scholar] [CrossRef]
- Almagro Armenteros, J.J.; Salvatore, M.; Emanuelsson, O.; Winther, O.; von Heijne, G.; Elofsson, A.; Nielsen, H. Detecting sequence signals in targeting peptides using deep learning. Life Sci. Alliance 2019, 2, e201900429. [Google Scholar] [CrossRef]
- Wang, Z.; Wei, S.; Reed, S.H.; Wu, X.; Svejstrup, J.Q.; Feaver, W.J.; Kornberg, R.D.; Friedberg, E.C. The RAD7, RAD16, and RAD23 genes of Saccharomyces cerevisiae: Requirement for transcription-independent nucleotide excision repair in vitro and interactions between the gene products. Mol. Cell. Biol. 1997, 17, 635–643. [Google Scholar] [CrossRef]
- Ramsey, K.L.; Smith, J.J.; Dasgupta, A.; Maqani, N.; Grant, P.; Auble, D.T. The NEF4 complex regulates Rad4 levels and utilizes Snf2/Swi2-related ATPase activity for nucleotide excision repair. Mol. Cell. Biol. 2004, 24, 6362–6378. [Google Scholar] [CrossRef]
- Lettieri, T.; Kraehenbuehl, R.; Capiaghi, C.; Livingstone-Zatchej, M.; Thoma, F. Functionally distinct nucleosome-free regions in yeast require Rad7 and Rad16 for nucleotide excision repair. DNA Repair 2008, 7, 734–743. [Google Scholar] [CrossRef]
- Verhage, R.; Zeeman, A.M.; de Groot, N.; Gleig, F.; Bang, D.D.; van de Putte, P.; Brouwer, J. The RAD7 and RAD16 genes, which are essential for pyrimidine dimer removal from the silent mating type loci, are also required for repair of the nontranscribed strand of an active gene in Saccharomyces cerevisiae. Mol. Cell. Biol. 1994, 14, 6135–6142. [Google Scholar] [CrossRef]
- Xie, Z.; Liu, S.; Zhang, Y.; Wang, Z. Roles of Rad23 protein in yeast nucleotide excision repair. Nucleic Acids Res. 2004, 32, 5981–5990. [Google Scholar] [CrossRef] [PubMed]
- Farmer, L.M.; Book, A.J.; Lee, K.H.; Lin, Y.L.; Fu, H.; Vierstra, R.D. The RAD23 family provides an essential connection between the 26S proteasome and ubiquitylated proteins in Arabidopsis. Plant Cell 2010, 22, 124–142. [Google Scholar] [CrossRef] [PubMed]
- Koga, A.; Ishibashi, T.; Kimura, S.; Uchiyama, Y.; Sakaguchi, K. Characterization of T-DNA insertion mutants and RNAi silenced plants of Arabidopsis thaliana UV-damaged DNA binding protein 2 (AtUV-DDB2). Plant Mol. Biol. 2006, 61, 227–240. [Google Scholar] [CrossRef] [PubMed]
- Teng, Y.; Liu, H.; Gill, H.W.; Yu, Y.; Waters, R.; Reed, S.H. Saccharomyces cerevisiae Rad16 mediates ultraviolet-dependent histone H3 acetylation required for efficient global genome nucleotide-excision repair. EMBO Rep. 2008, 9, 97–102. [Google Scholar] [CrossRef]
- Ghodke, H.; Wang, H.; Hsieh, C.L.; Woldemeskel, S.; Watkins, S.C.; Rapić-Otrin, V.; Van Houten, B. Single-molecule analysis reveals human UV-damaged DNA-binding protein (UV-DDB) dimerizes on DNA via multiple kinetic intermediates. Proc. Natl. Acad. Sci. USA 2014, 111, E1862–E1871. [Google Scholar] [CrossRef]
- Boiteux, S.; Jinks-Robertson, S. DNA repair mechanisms and the bypass of DNA damage in Saccharomyces cerevisiae. Genetics 2013, 193, 1025–1064. [Google Scholar] [CrossRef]
- Zhang, L.; Gong, F. The emerging role of deubiquitination in nucleotide excision repair. DNA Repair 2016, 44, 118–122. [Google Scholar] [CrossRef]
- Fadda, E. Role of the XPA protein in the NER pathway: A perspective on the function of structural disorder in macromolecular assembly. Comput. Struct. Biotechnol. J. 2015, 14, 78–85. [Google Scholar] [CrossRef]
- Sugasawa, K.; Akagi, J.; Nishi, R.; Iwai, S.; Hanaoka, F. Two-step recognition of DNA damage for mammalian nucleotide excision repair: Directional binding of the XPC complex and DNA strand scanning. Mol. Cell 2009, 36, 642–653. [Google Scholar] [CrossRef]

| Genotypes | Wt. Green Seeds | Empty Spots | Small White Dot | Small Brown | Medium Brown | Total |
|---|---|---|---|---|---|---|
| Col | 870 | 0 | 0 | 0 | 0 | 870 |
| rad16-2 | 740 (99.6 %) | 0 | 0 | 3 (0.4%) | 0 | 743 |
| rad16-2 rad23b/+ | 600 (75.09%) | 10 (1.25%) | 10 (1.25%) | 79 (9.88%) | 100 (12.51%) | 799 |
| rad23b | 780 | 0 | 0 | 0 | 0 | 780 |
| Rad23b rad16-2/+ | 589 (78.22%) | 6 (0.79%) | 3 (0.39%) | 73 (9.69%) | 82 (10.88%) | 753 |
Disclaimer/Publisher’s Note: The statements, opinions and data contained in all publications are solely those of the individual author(s) and contributor(s) and not of MDPI and/or the editor(s). MDPI and/or the editor(s) disclaim responsibility for any injury to people or property resulting from any ideas, methods, instructions or products referred to in the content. |
© 2023 by the authors. Licensee MDPI, Basel, Switzerland. This article is an open access article distributed under the terms and conditions of the Creative Commons Attribution (CC BY) license (https://creativecommons.org/licenses/by/4.0/).
Share and Cite
Alrayes, L.; Stout, J.; Schroeder, D. Arabidopsis RAD16 Homologues Are Involved in UV Tolerance and Growth. Genes 2023, 14, 1552. https://doi.org/10.3390/genes14081552
Alrayes L, Stout J, Schroeder D. Arabidopsis RAD16 Homologues Are Involved in UV Tolerance and Growth. Genes. 2023; 14(8):1552. https://doi.org/10.3390/genes14081552
Chicago/Turabian StyleAlrayes, Linda, Jake Stout, and Dana Schroeder. 2023. "Arabidopsis RAD16 Homologues Are Involved in UV Tolerance and Growth" Genes 14, no. 8: 1552. https://doi.org/10.3390/genes14081552
APA StyleAlrayes, L., Stout, J., & Schroeder, D. (2023). Arabidopsis RAD16 Homologues Are Involved in UV Tolerance and Growth. Genes, 14(8), 1552. https://doi.org/10.3390/genes14081552

